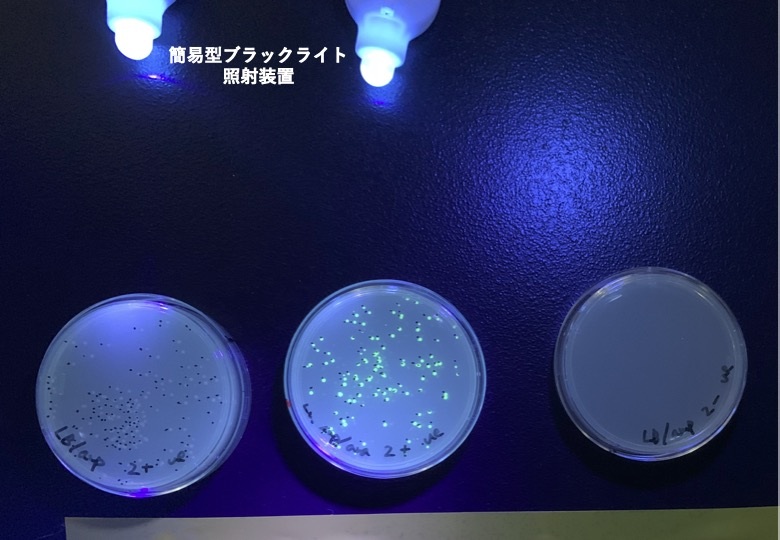

公開講座「学校教員のための遺伝子組換え実験教育研修会」を開催
2025年10月23日
7月24日(木)から25日(金)に公開講座「学校教員のための遺伝子組換え実験教育研修会」が開催され、中学・高等学校(都道府県の教育センターを含む)の理科系教員10名が参加しました。
本研修会は「教育目的組換えDNA実験」のガイドラインが文部科学省で制定された2001年に、筑波大学遺伝子実験センターと東京農工大学遺伝子実験施設が全国の国立大学遺伝子実験施設に先駆けて開催したもので、今年で24回目となります。
研修ではリテラシーとしての遺伝子教育を目標とした教材を用いて、オワンクラゲ由来の緑色蛍光タンパク質(GFP)の遺伝子を含むプラスミドDNAを大腸菌に導入し、翌日に大腸菌のコロニーを観察しました。紫外線(ブラックライト)照射下でプレート上の大腸菌のコロニーが緑色の蛍光を放つ様子から、培地に誘導物質(アラビノース)を含む場合にのみ遺伝子発現が誘導され、緑色蛍光タンパク質が合成されたと知ることができます(写真2 中央のプレート)。
用いる簡易型ブラックライト照射装置の入手方法や、中学・高校の教育現場での工夫について等、講義や実習中の質疑応答を通して活発な意見交換と情報共有が行われました。
今回の研修を受講された教員の指導のもと、中学・高校の授業において本実験が実施されることで、生徒たちの分子生物学への関心が一層高まることが期待されます。